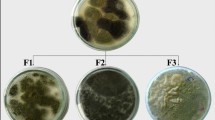

Abstract
Two fungal species were isolated from the studied rock samples and identified morphologically as Aspergillus hollandicus and Penicillium citrinum. Bioleaching process was applied to W1, W2 and W3. The average concentration activity of 238U, 226Ra, 232Th, and 40K are 5134.03, 5708.64, 189.51, and 1456.8 BqKg−1, respectively. Radionuclide’s distribution in leach liquor, residual, and fungal adsorption were followed and environmental hazard indices (Raeq, Iγ, Hex, Hin, and ECLR) were calculated. From the observed outcomes, the isolated fungal strains have the potential to reduce the harmful effect up to 50% compared to the original. As a result, application of these fungal strains offers a potential strategy for environmental remediation of radionuclides.
Similar content being viewed by others
Avoid common mistakes on your manuscript.
Introduction
Radionuclide contamination has become a part of the surrounding environment in the form of fallout from nuclear weapons, waste from nuclear energy-generating industries, and from medical uses of radioisotopes. Fungi play a significant role in providing ecosystem services in terrestrial ecosystems [1], the importance of organic soil horizons and their microbial communities (fungi and bacteria) highlighted as potential accumulators of nutrient elements and radionuclides within terrestrial ecosystems [2]. According to Steinera et al. [3], fungi are one of the most crucial elements of forest ecosystems because they greatly influence the transit pathways and fate of radionuclides. The immobilization process of radionuclides achieved by saprotrophic fungi, which present in the surrounding environment depends on its ability to increases enormous surface area of hyphae that fitting them for absorbing a large amount of nutrient elements and radionuclides from the environment [4, 5].
One of the main issues regarding ecotoxicology and human health is radionuclides in the environment. Consequently, the use of fungi in bioremediation of radioactively contaminated sites and cleanup of an industrial effluent is one of the most important requirements [6], Although heavy metals are naturally present in the soil, geologic and anthropogenic activities increase the concentration of these elements to amounts that are harmful to both plants and animals. Among there are the mining and smelting of metals, the burning of fossil fuels, the use of pesticides and fertilizers in agriculture, the manufacturing of batteries and other metal products in the industrial sector, and the disposal of sewage sludge [7].
Bioremediation happens spontaneously and is enhanced by providing live substances and fertilizers where the main principle behind biodegradation technology is bioremediation. It means total elimination of hazardous organic pollutants into nontoxic, naturally existing, or innocuous substances like carbon dioxide, water, and inorganic substances that are secure for use by people, animals, plants, and aquatic life [8] as well as the degradation of the contaminants is mediated by physical or enzymatic- regulated processes such as bioaccumulation, biosorption, biomineralization, and biotransformation [9]. Qayyum et al. [10] showed that the industrial soil contaminated with heavy metals may be considered a valuable natural source of resistant fungal strains like Rhizomucor pusillus, Aspergillus flavus, Aspergillus terreus, Aspergillus tubingensis, and Neosartorya hiratsukae, which can be widely used as a bioleaching or bioremediation tool. There are numerous studies that used microorganism like fungi in bioremediation process such as El Dabour et al. [11] were applied Aspragillus species on the waste samples that collected from Allouga locality southwestern Sinai, Egypt and demonstrated that A. lentulus had a higher bioleaching efficiency of uranium (68%) than A.niger (54%). Attia et al. [12] utilizing a natural fungus strain, Aspergillus nidulans, as a green technology, the uranium bioleaching efficiency was established at 80% under the ideal conditions of 3 pH, 3% pulp density, 7 days of incubation, and 30 °C incubation temperatures. On the other hand, the microorganism was utilized in the wastewater treatments as biosorption and/or bioaccumulation of contamination through its mycelium, which applied in different fields as pharmaceutical industry, dyes removal, agriculture as pesticides degradation, and metal removal (Th, Ra, U, Cu, Zn, Cd, Pb, Fe, Ni, and Ag) [13] by the mechanism of producing two main types of extracellular chemicals in response to metal stress known as microbial extracellular polymeric substances (EPS) and soluble microbial products (SMP), which affecting the metal binding properties to their active sites [14] as well as the biodegradation of a wide range of organic molecules has been explained by several mechanisms and pathways; for instance, it can occur both with and without oxygen [15].
The natural decay of uranium (238U and 235U) series, thorium (232Th) series, and singly occurring isotopes like potassium (40K) Khandaker et al. [16] contributed that the most of these invisible radiation sources cause environmental pollution.
The aim of this work is to study the relation between the bioleaching process and radionuclides behavior using two fungal isolates; A.hollandicus and P. citrinum, from the rock samples that collected from Gabal Um Hamd, Sinai, Egypt in addition to calculate their effects on the health hazard indices.
Geological setting
Gabal Um Hamd in southwest Sinai is where the rock samples were collected. Primary and secondary minerals that are allogenic and authigenic make up the research region in Um Hamd, as seen in Fig. 1 radioactive (U, Th), non-radioactive REEs, and base metal-bearing minerals [17]. A lower siltstone-Fe, Mn ore member, a middle siltstone-mudstone-shale member, and an upper dolostone-dolomitic limestone member might all be classified as parts of the Um Bogma Formation in Gabal Um Hamd. In the western region of Gabal Um Hamd, where the middle and upper members are the thinnest, otherwise the bottom member, which exhibits an increase in thickness. The three members' rocks vary in their levels of Fe oxide and to a lesser extent of Mn-bearing deposit richness [18]. The Um Bogma Formation's sediments underwent a variety of diagenetic processes, including both iso-chemical and allo-chemical processes. The lower member indicates a maritime habitat that is subtidal to intertidal. The shallow subtidal marine habitat follows the open ocean shelf environment in the middle member. The upper member has shallow subtidal to lower intertidal environments, which are followed by clastic rocks that suggested a regressive sea within a tidal flat [19].
Geological map showing the location of the studied area and samples location (Modified after Hamza et al., [17])
Methodology
Samples preparation
Three geologically gripped radioactive rock samples were collected from Gabal Um Hamd in southwest Sinai. Each sample is a representation of the location where it was gathered. The samples were sealed in sterile polyethylene packets before being crushed, quartered, and ground for analysis. The specification of the studied samples was as follows: i) The first sample (W1) is composed of compact siltstone, which is medium hard and highly feriginous, ii) The second sample (W2) is made up of grey shale, which is fissile ferruginous and gypsiferrous, and iii) The third sample (W3) is made up of sandy dolostone, which is jointed and fractured and is dark grey.
Microbiological studies
The microbial studies upon the collected samples were explained in three steps as follows:
Step1: Fungal isolation
Fine ore powder was spread directly upon the surface of sabouraud dextrose agar plate, this agar media is particularly useful for fungal regrowth [20, 21], in which under septic conditions, sealed and incubated at 30 ºC until the fungal colonies grew [22, 23].
Step2: Purification and identification of isolated fungi
Hyphal tips of each colony were removed and plated upon the surface of sabouraud agar plates. The developed colonies were examined under a microscope to detect contamination. The pure isolated colonies were identified at the regional center for mycology and biotechnology (RCMB) Al-Azhar-University, Cairo, Egypt [23,24,25]. The microbiological experiments included the fungal strains isolation from the studied rock samples are followed by the bioleaching process.
Step3: Impact of fungi on the test for Bioleaching Ability
Studying the behaviors of isolated fungal strains from studied rock samples (W1, W2 and W3), which contain different grades (high, moderate, and low) of uranium and thorium concentrations. Using 100 g of ore from each sample was placed in a1000 mL Erlenmeyer flask then, adding three hundred ml of sabouraud dextrose media to be autoclaved. Inoculation of 10% (v/v) of 1 × 108 spore/mL from each fungus separately with each sample in a separate flask. bioleaching factors investigated included: ore concentration 3%, 1/3 solid liquid ratio, incubation period 7 days at temperature between 30 and 35 °C and pH value equals 3, which applied to the determined optimum conditions.
The radionuclides activity concentrations for the original samples (BqKg−1), bioleach liquor (BqL−1), fungal biosorption (BqKg−1), and residual (BqKg−1) because of bioleaching process phases will be measured using a high-purity germanium (HPGe) detector as a non-destructive examination. The relative efficiency of this detector, which has a resolution of 1.90 keV and a relative efficiency of approximately 50% of the 3′′ 3′′ NaI (Tl) crystal efficiency, was used to determine the activity concentrations of various radionuclides, including 238U, 235U, 234Th, 234 Pa, 232Th, 226Ra, and 40K. The peak/Compton ratio is 69.9 at 1.33 MeV based on 60Co is changing [26].
Radiation hazard indices factors
Absorbed dose rate (DR)
The absorbed dose rate (nGy/h) for the current study has been caculated using Eq. (1)
where AU, ATh, and AK are the average specific activities of 226Ra, 232Th, and 40K respectively in Bq kg−1, respectively [27, 28].
Annual effective dose equivalent (AEDE)
Annual effective dose due to radionuclides activities for different studied samples are calculated for outdoor or indoor using Eq. 2, the conversion factor from absorbed dose in air to effective dose must be taken in unit of mSv per year, is calculated from the following Eq. (2) [27, 28].
where mSvy−1 is the effective dose rate, (n Gy h−1) is the dose rate and SvGy−1 is the conversion coefficient.
Excess lifetime cancer risk (ELCR)
Excess lifetime cancer risk gives the probability of developing cancer over a lifetime at a given exposure level, considering 70 years as the average duration of life for human beings, as displayed in Eq. (3) [29].
where AEDE is the Annual Effective Dose Equivalent, DL is the average Duration of Life (estimated to be 70 years) and RF is the Risk Factor (Sv) represents fatal cancer risk per Sievert. For stochastic effects, ICRP uses RF as 0.05 for the public.
Radium equivalent activity (Raeq)
The combined specific activity of 226Ra, 232Th, and 40K develop a numerical indicator of an external dose to public [23, 30]. Suggested Eq. (4), to calculate radium equivalent and stated the value of 370 Bq kg−1 as the maximum allowed dose public.
where ARa, ATh and AK are the specific activities of 226Ra, 232Th and 40K, in Bq Kg−1, respectively.
External hazard (Hex)
External hazard index (Hex) are used to measure the external hazard due to the emitted gamma radiation, which has been calculated for the present study using Eq. (5) [27].
where Hex is the external hazrd index and ARa, ATh and AK are the specific activity of 226Ra, 232Th and 40K in Bq Kg−1, respectively.
Internal hazard (Hin)
The internal radon and its daughter products are quantified by the internal hazard index Hin, which is caculated for the studied samples in the present study using Eq. (6):
I-gamma (Level Index)
It is also possible to use an activity utilization index proposed by EC [31] and UNSCEAR [27] due to the raw materials used in building and covering materials, that facilitates the derivation of dose rates in air from different combinations of these three radionuclides has been caculated for the different studied samples using Eq. (7)
where CK, CU and CTh are the specific activities of 226Ra, 232Th and 40K respectively in Bqkg−1 due to building materials. The safty vlue of this index is ≤ 1 [32].
Results and discussion
The microbiological experiments included the fungal strains isolation from the studied rock samples are followed by the bioleaching ability assay.
Microorganisms isolation and identification
Two fungal species were isolated from the tested samples. The most dominant fungal strains belong to two species, known as Asperigillus and Penicillium, identified according to their morphological features, (RCMB), meanwhile, the first one of Aspergillus species was identified as Aspergillus hollandicus (A. hollandicus) and the second of Penicillium species as Penicillium citrinum (P. citrinum). They were grown in the presence of sabouraud agar medium at 30−35°C for 7 days.
Gamma counting
The obtained results for the activity concentrations of 238U, 226Ra, 235U, 232Th, and 40K as well as their averages are reported in Table 1 respectively (Bq Kg−1) for the studied rock samples (W1, W2, And W3) by HPGe detector, the radionuclides distribution for different studied samples shown in (Fig. 2). For the sample W1 the activity concentration of 238U, 226Ra, 235U, 232Th and 40K was 2982, 3011,136, 102.6, and 744 Bq Kg−1, respectively. The activity concentration of W2 was 4765.73, 5358.12, 216.09, 198.1, and 1723 Bq Kg−1, respectively. Finally, for the sample W3 the activity concentration was 7654.3, 8756, 347.91, 267, and 1903 Bq Kg−1, respectively. There are respective world-wide concentration limitations of 33, 32, 45, and 420 Bq Kg−1 for 238U, 226Ra, 232Th, and 40K [27]. The obtained data demonstrates that it is obvious that Sandy dolostone, jointed and fractured (W3), have the highest concentration of uranium, thorium, radium, and potassium. The obtained results of ore samples for the activity concentrations showed that all the studied radionuclides in the representative samples have higher values relative to that recorded in the UNSCEAR [27]. As a result, it has higher concentrations of uranium and thorium than sediments described in the IAEA's [33] publication, but lower 40K levels. The Fe oxide cement is also attached to and/or adsorbed with some uranium content.
Fractional dissolution of radionuclides during bioleaching process
Results of specific activities of various isotopes have been examined for each different phase of the bioleaching process: (a) bioleach liquor phase (Bq L−1), (b) fungal biosorption phase (Bq Kg−1) and (c) residual phase (Bq Kg−1) shown in Fig. 3. Leachability percentage for each radionuclide was adjusted varied using A. hollandicus, as listed in a group of Tables 2, 3, 4, the investigated measurements with the following characteristics:
-
(i)
Table 2 for sample W1, which recorded radionuclides leachability percent are 69%, 72%, 46%, and 69% for 238U, 226R, 232Th and 235U, respectively. The calculated activity ratio of 238U/235U exhibited within the natural value between 20.00 and 21.92, which reflects a slight deviation from the natural ratio (21.7). Activity ratio of 226Ra/238U recorded 1.009, 0.92, 1.07, and 1.009 for original sample, residual, bioleach liquor, and fungal biosorption, respectively. It is clear from the activity ratio that the calculated values come close to the unity that attained to secular equilibrium while ratio of 238U/232Th ranged from 16.01 to 60.55 showed a deviation from the natural (magmatic) ratio 1:3 in the direction of U-migration-in [11].
-
(ii)
The radionuclides leachability percent for sample W2 are recorded 49%, 53%, 28%, and 48% for 238U, 226R, 232Th and 235U, respectively are shown in Table 3, as well as the calculated ratio of 238U /235U exhibited slightly higher values than the natural value (21.7) between 22.05 and 24.01. the 226Ra/238U ratio recorded 1.12, 1.05, 1.18, and 1.51 for original sample, residual, bioleach liquor, and fungal biosorption, respectively, while the ratio of 238U /232Th ranged from 15.26 to 51.58.
-
(iii)
The sample W3 recorded radionuclides leachability percent are 46%, 50%, 25% and 46% for 238U, 226R, 232Th and 235U respectively as in Table 4. The calculated ratio of 238U/235U exhibited within the natural value (21.7) between 22.00 and 22.59. The 226Ra/238U ratio recorded 1.14, 1.08, 1.22, and 1.59 for original sample, residual, bioleach liquor, and fungal biosorption, respectively, while the ratio of 238U /232Th ranged from 14.21 to 59.60.
On the other hand, the calculated leachability is varied for each radionuclide using P. citrinum as follows:
-
(i)
Table 5 shown the sample W1, which recorded radionuclides leachability percent are 56%, 68%, 33%, and 55% for 238U, 226R, 232Th, and 235U, respectively. The calculated ratio of 238U /235U exhibited within the natural value (21.7) between 20.07 and 22.83. The 226Ra/238U ratio recorded 1.01, 0.72, 1.30, and 1.01 for original sample, residual, bioleach liquor, and fungal biosorption, respectively. The ratio of 238U/232Th ranged from 17.43 to 52.48.
-
(ii)
The sample W2 recorded that the radionuclides leachability percentage are 24%, 36%, 33%, and 24% for 238U, 226R, 232Th, and 235U, respectively (Table 6). As well as the calculated ratio of 238U /235U exhibited between 22.05 and 22.33. The 226Ra/238U ratio recorded 1.12, 0.99, 1.28, and 2.39 for original sample, residual, bioleach liquor, and fungal biosorption, respectively. the ratio of 238U/232Th ranged from 13.90 to 51.01. Finally,
-
(iii)
Table 7 demonstrated a sample W3 with the recorded radionuclides leachability percent that achieved 71%, 72%, 16%, and 71% for 238U, 226R, 232Th and 235U respectively. The calculated ratio of 238U/235U exhibited between 21.91 and 22.00. The 226Ra/238U ratio recorded 1.14, 1.79, 1.15, and1.08 for original sample, residual, bioleach liquor, and fungal biosorption, respectively. The ratio of 238U/232Th ranged from 22.59 to 60.58.
From the obtained results of the radionuclides activity concentrations of the studied samples and different bioleaching phases, numerous useful ratios as 238U/235U, 226Ra/238U, and 238U/232Th were calculated. 238U/235U ratios demonstrated that the predominant normality was achieved for each phase around the natural value (21.7) deducing the same behavior of the two radioactive elements [34,35,36]. Also, the 226Ra/238U ratio represents a meaningful ratio in the geological systems whereas its normal value equals unity, if any deviation is recorded whether greater or lesser pointing to deviation from the secular equilibrium, may be that due to 226Ra in excess of equilibrium with 238U enhanced leaching of 224U according to the occurring of alpha decay- recoil phenomenon causing nucleus damage to the crystal structure of the ore [37]. Finally, the obtained ratio 238U/232Th are compared with the ratio in the upper crust is typically 0.8 [38] indicating a relatively enhancement of 238U to 232Th. Therefore, the slight enhancement of uranium relative to thorium in some samples may be due to dissolution and re-adsorption of uranium.
Radiological hazards (EhzIs)
From Table 8 The absorbed dose rate was ranged from (2666.83–4286 n Gy/h), and the annual effective dose equivalent calculated for outdoor from 1.82 to 5.25 mSv/y. Since the results of absorbed dose rate (DR) and the annual effective dose rate (AEDE) are higher than the international recommended values, which are 60 n Gy/h and 1 mSv/y, respectively [27, 28].
The Level index I-gamma calculated values were ranged from 21.59 to 62.3, which found to be higher than the world level index I-gamma (Iγ ≤ 6) [27]. The obtained values for calculated Hex ranges from 8.96 to 25.09 are higher than the world external hazard (unity) [27], likewise, the values of internal hazard index (Hin) ranges from 16.44 to 25.09 are higher than the world internal hazard unity, as well as the radium equivalent activity (Raeq) ranged from ( 3728.86 Bq Kg−1) to (10,603.12 Bq Kg−1), which is higher than the recommended maximum value (370 Bq Kg−1) [26]. The value of the excess life cancer risk (ELCR) varied from (6.37 × 10–3 to 18.39 × 10–3), which is greater than the standard ELCR that is given as (0.29 × 10–3) [29]. From the previous results can be concluded that A. hollandicus decreased the AEDE value in the three studied samples as in Table 9. For sample W2 and W3 the value of DR, AEDE, Iγ, Hex, Hin, Raeq, and ECLR in residual phase was higher than that in the leach liquor represented low leachability percentage. On the other hand, the calculated hazard indices using P. citrinum, exhibited an effective role in decreasing the DR, AEDE, Iγ, Hex, Hin, Ra eq in the residual phase R1 as (497.84 n Gy/h), (0.61 mSv/y), (7.28), (5.49), (2.92), (1278.9BqKg−1), and (2.13 × 10–3), respectively. and R3 as (957.76 n Gy/h), (1.17 mSv/y), (14.19), (9.95), (5.60), (3265.53 BqKg−1), and (4.11 × 10–3). As well as in fungal biosorption phase whereas it has high values of DR, AEDE, Hex, Hin, Raeq, also in B2 as (461.11nGy/h), (0.56 mSv/y), (5.11), (2.71), and (1179.83BqKg−1), respectively. These results agreed with Maity et al. [39], showed that high doses of gamma radiation cause dose-dependent inhibitory effects in the fungi that make soil fungal community structure appeared to shift toward species that may be more radiation resistant, and melanin-containing fungi ascended to dominate the soil fungal communities with increase in radionuclide pollution [40].
Furthermore, the obtained results of the bioleaching process, the effect of both two studied fungi upon the environmental hazard indices (EhzIs) were observed (Fig. 4). Firstly, the effect of A. hollandicus was achieved a significantly decreasing of the EhzIs percentage in different bioleaching phases. (i) The leach liquor (L1, L2, and L3) approached to 46% as a reduced value comparing with the original samples hazard indices and (ii) the fungal phase similarly recorded decreasing of their percentage as 25% (B1), 6% (B2), and 4% (B3). Consequently, concluded that the bioleaching process can clean up (remediate) the original samples by 70%, 51%, and 49% for W1, W2, and W3, respectively. Likewise, the remaining percentage values of EHzIs in the residual achieved 29%, 49%, and 54% for W1, W2, and W3, respectively. Secondly, in the same manner, the effect of P. citrinum, was significantly decreasing the environmental hazard indices (EhzIs) percentage in different bioleaching phases. The leach liquor (L1, L2, and L3) recorded 52%, 19%, and 65% as a reduced value comparing with ore hazard indices and the fungal phase recorded decreasing percentage as 14% (B1), 17% (B2), and 3% (B3) comparing with the original samples. As result, bioleaching process can clean up (remediate) the original samples by 83%, 50%, and 72% for W1, W2, and W3, respectively. Therefore, the remaining percentage values of EhzIs in the residual achieved 33, 63, 22% for W1, W2, andW3, respectively.
Conclusion
Bioremediation will be required as a highly effective way of pollutant removal and nutrient recycling in an ecosystem. Fungi, as decomposers have the unusual capacity to metabolize various organic and inorganic contaminants, which utilizing them as energy and carbon sources as well as reducing them to non-hazardous concentrations. Radiometric studies clearly show high values of uranium contents in the rock samples and bioleaching process phases (leach liquor, residual, and fungal adsorption) relative to those international recorded values. The EHzIs were calculated for the original samples cleared that (DR), (AEDE) and (Raeq) were more than the international recommended limits. The effect of the two fungal isolates upon radionuclides were followed in the three phases of bioleaching process showed that A. hollandicus exhibited a high leaching efficiency with low uranium contents samples as well as achieved a low leaching efficiency with high uranium content samples. Since P. citrinum can withstand the high uranium content samples, also it exhibited a high leachability of uranium whereas displays a better result to decrease the EHzIs in the studied samples. Consequently, can utilize the P. citrinum to remediate the environment by applying bioleaching process several times to reach the safe international limit values of EHzIs. The hazard indices in leach liquor phase are directly proportional to the leachability percentage otherwise in the case of residual phase are inversible. Therefore, it is recommended to use a combined leaching experiment and hazard index calculation as an indicator of fungal leaching efficiency.
References
Dighton J (2019) Fungi and remediation of radionuclide pollution. In fungal bioremediation (pp 238–263), CRC Press
Dulanská S, Gomola I, Gubišová M, Ondreičková K, Pánik J, Mátel Ľ, Horník M (2022) Uptake and distribution of radiostrontium in tomato treated with arbuscular mycorrhizal fungi. Radiat Prot Dosim 198(9–11):720–725. https://doi.org/10.1093/rpd/ncac125
Steinera M, Linkovb M, Yoshida S (2002) The role of fungi in the transfer and cycling of radionuclides in forest ecosystems. J Environ Radioact 58:217–241. https://doi.org/10.1016/s0265-931x(01)00067-4
Witkamp M, Barzansky B (1968) Microbial immobilization of 137cs in forest litter. Oikos 19(2):392–395. https://doi.org/10.2307/3565024
Formann S G (2016) Sequestration of heavy metals and radionuclides in ectomycorrhiza (Doctoral Dissertation, Dissertation, Jena, Friedrich-Schiller- Universität Jena
Dighton J, Tugay T, Zhdanova N (2008) Fungi and Ionizing radiation from radionuclides. FEMS Microbiol Lett 281(2):109–120
Chibuike GU, Obiora SC (2014) Heavy metal polluted soils: effect on plants and bioremediation methods. Appl Environ Soil Sci 2014:1–12
Pankaj KJ, Vivek B (2012) Biotechnology of bioremediation a review. Int J Environ Sci 3:535–549 (Link: Https://Goo.Gl/Ehlwbz)
Shourie A, Vijayalakshmi U (2022) Fungal diversity and its role in mycoremediation. Geomicrobiol J 39(3–5):426–444
Qayyum S, Khan I, Maqboo F, Zhao Y, Gu Q, Peng C (2016) Isolation and characterization of heavy metal resistant fungal isolates from industrial soil in China. Pak J Zool 48(5)
El Dabour SE, Harpy NM, Nada A, Sallam AM, El Aassy EI, El Feky MG (2019) Radiometric and microbiological investigations of ore and waste samples with especial emphasis on suitable fungus for remediation processes. J Sci Res Sci 36(1):274–285
Attia RM, Sallam OR, Abbas AEA, Kawady NA (2022) Comparative evaluation of chemical and bio techniques for uranium leaching from low grade sandstone rock sample, Abu Thor, southwestern Sinai Egypt. J Radioanal Nucl Chem 331(12):5675–5689
Bibbins-Martínez M, Juárez-Hernández J, López-Domínguez JY, Nava-Galicia SB, Martínez-Tozcano LJ, Juárez-Atonaľ R, Cortés-Espinosa D, Díaz-Godinez G (2023) Potential application of fungal biosorption and/or bioaccumulation for the bioremediation of wastewater contamination: a review. J Environ Biol 44(2):135–145
Zadeh PH, Fermoso FG, Collins G, Serrano A, Mills S, Abram F (2023) Impacts of metal stress on extracellular microbial products, and potential for selective metal recovery. Ecotoxicol Environ Saf 252:114604. https://doi.org/10.1016/j.ecoenv.2023.114604
Abatenh E, Gizaw B, Tsegaye Z, Wassie M (2017) The role of microorganisms in bioremediation—a review. Open J Environ Biol 2(1):038–046
Khandaker MU, Jojo PJ, Kassim HA (2012) Determination of primordial radionuclides in natural samples using HPGe gamma ray spectrometry. APCBEE Proc 1:187–192. https://doi.org/10.1016/j.apcbee.2012.03.030
Hamza MF, Sallam OR, Khalafalla MS, Abbas AE, Wei Y (2020) Geological and radioactivity studies accompanied by uranium recovery: Um Bogma formation, southwestern Sinai. Egypt J Radioanal Nucl Chem 324:1039–1051
Abu-zeid MM, El Aassy IE, Aly GA, Abu Zeid EK, Baghdady AR, Ahmed AR (2018) Geology, petrography and mineralogy of the uraniferous Um Bogma formation in Gabal Um Hamd, Southwestern Sinai. Egypt Egypt J Geol 62:191–215
Mostafa MH, Aita SK, Farhat HI, Kharbish S (2021) Sedimentological studies of early carboniferous Um Bogma formation, Southwestern Sinai. Egypt IOSR J Appl Geol Geophys 9:65–74
Sabouraud K (1892) Ann Dermatol. Syphilol 3:1061
Pharmacopeia U S (1985) 21st revision, USP convention, ed. Rockville, MD, 1893–1895
Gilman J (1957) A manual of soil fungi. Soil Sci 84(2):183
Pitt JI (1979) The genus penicillium and its teleomorphic states eupenicillium and talaromyces. Academic Press Inc., Ltd
Domsch KH, Gams W, Anderson TH (1993) Compendium of soil fungi
Samson RA, Hoekstra ES, Frisvad JC (2004) Introduction to food-and airborne fungi (No. Ed. 7). Centraalbureau voor Schimmelcultures (CBS)
Aly HS, Abd El Ghaffar NI, Abdel Maksod T, Ismail AIM (2021) Radiometry analysis of alluvial deposits samples collected from Sharm El-Sheikh area. South Sinai Egypt Curr Sci Int 10(3):414–424. https://doi.org/10.36632/csi/2021.10.3.36
United Nations Scientific Committee on the Effects of Atomic Radiation (2010) Report of the united nations scientific committee on the effects of atomic radiation (UNSCEAR)
Bajoga A, Al-Dabbous A, Abdullahi A, Alazemi N, Bachama Y, Alaswad S (2019) Evaluation of elemental concentrations of uranium, thorium and potassium in topsoils from Kuwait. Nucl Eng Technol 51(6):1636–2164
Taskin HM, Karavus P, Ay A, Touzogh S, Hindiroglu and Karaham G (2009) Radionuclide concentration in soil and lifetime cancer risk due to gamma radioactivity in Kirklareli, Turkey. J Environ Radioact 100:49–53
Beretka I, Mathaw PI (1985) Natural radioactivity of australian building materials, industrial wastes and by-products. Health Phys 48:87–95
EC-European Commission. (1999). Radiological protection principles concerning the natural radioactivity of building materials. Radiat Prot 112
Bassioni G, Mohammed FS, Al Zubaidy E, Kobrsi I (2012) Risk assessment of using aluminum foil in food preparation. Int J Electrochem Sci 7(5):4498–4509
International Atomic Energy Agency (1979) Atomic Energy Review, Vol. 17, No. 4, Atomic Energy Review, IAEA, Vienna
Georgakopoulos A (2000) The Drama lignite deposit, Nothern Greece: insights from traditional coal analyses, rock-eval data, and natural radionuclides concentrations. Energy Sources 22:497
Tsikritzis LI, Fotakis M, Tzimkas N, Kolovos N, Tsikritzi R (2008) Distribution and correlation of the natural radionuclides in a coal mine of the West Macedonia lignite center (Greece). J Environ Radioact 99:230–237
El Aassy I, El Galy M, Nada A, El Feky M, Abd El Maksoud T, Talaat S, Ibrahim E (2011) Effect of alteration processes on the distribution of radionuclides in uraniferous sedimentary rocks and their environmental impact, southwestern Sinai. Egypt J Radioanal Nucl Chem 289(1):173–184
Papadopoulos A, Christofides G, Koroneos A, Stoulos S, Papastefanou C (2013) Radioactive secular equilibrium in 238U and 232Th series in granitoids from Greece. Appl Radiat Isot 75:95–104
Porcelli D, Swarzenski PW (2003) The behavior of U-and Th-series nuclides in groundwater. Rev Mineral Geochem 52(1):317–361
Maity JP, Chakraborty S, Kar S, Panja S, Jean JS, Samal AC, Santra SC (2009) Effects of gamma irradiation on edible seed protein, amino acidsand genomic DNA during sterilization. Food Chem 114(4):1237–1244
Zhu J, Sun X, Zhang ZD, Tang QY, Gu MY, Zhang LJ, Yuan HL (2021) Effect of ionizing radiation on the bacterial and fungal endophytes of the halophytic plant Kalidium schrenkianum. Microorganisms 9(5):1050
Funding
Open access funding provided by The Science, Technology & Innovation Funding Authority (STDF) in cooperation with The Egyptian Knowledge Bank (EKB).
Author information
Authors and Affiliations
Corresponding author
Additional information
Publisher's Note
Springer Nature remains neutral with regard to jurisdictional claims in published maps and institutional affiliations.
Rights and permissions
Open Access This article is licensed under a Creative Commons Attribution 4.0 International License, which permits use, sharing, adaptation, distribution and reproduction in any medium or format, as long as you give appropriate credit to the original author(s) and the source, provide a link to the Creative Commons licence, and indicate if changes were made. The images or other third party material in this article are included in the article’s Creative Commons licence, unless indicated otherwise in a credit line to the material. If material is not included in the article’s Creative Commons licence and your intended use is not permitted by statutory regulation or exceeds the permitted use, you will need to obtain permission directly from the copyright holder. To view a copy of this licence, visit http://creativecommons.org/licenses/by/4.0/.
About this article
Cite this article
Mohamed, W.S., Abbas, Y.M.M., Ammar, A.A.A. et al. Effect of fungal isolates from different samples upon radionuclide behavior and environmental hazard indices during bioleaching process in Gabal Um Hamd, Um Bogma area, southwestern Sinai, Egypt. J Radioanal Nucl Chem 332, 3919–3932 (2023). https://doi.org/10.1007/s10967-023-09090-1
Received:
Accepted:
Published:
Issue Date:
DOI: https://doi.org/10.1007/s10967-023-09090-1